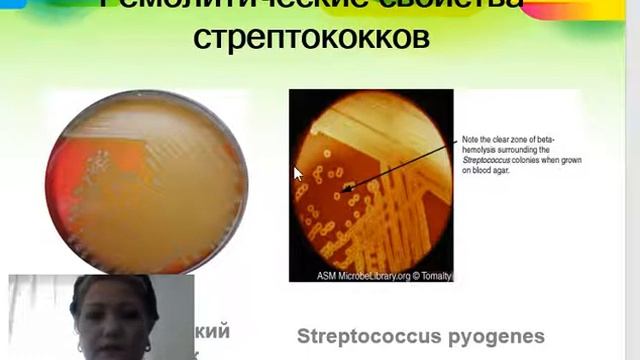
Патогенные кокки смотреть онлайн

Автор: Путешествия по невидимому миру Страница 2

WAIT!! THAT'S NOT FOOD!!! ?? (Incredible Feast)

204?Послание от Господа "И вот закрою двери! И благодать отнимется уже!"

кто подложил свинью

Квашеная капуста, получается всегда хрустящая и вкусная

??Итальянские пословицы? Интересный урок. Итальянский язык

САДОВОД/ПОСУДА 1 ЧАСТЬ /ОПТ И РОЗНИЦА/НОВИНКА 2019Г/РЫНОК САДОВОД/МОСКВА

Почему быть девушкой неудобно?

ЭЛЬВИРА - ПОВЕЛИТЕЛЬНИЦА ТЬМЫ

Шок такого я еще не видел ловля раков на раколовки

Замутил с соседкой на Новый год / Истории из жизни людей / Рассказы из жизни

MOM & BABY BOX 2016 - Senya Miro

Купил Apple Watch SE в МегаМаркете - Что с ними не так?

Грузди.Прогулка по лесу

как сломать руку?

4 ЧАСА ИГРАЮ в КАСТОМКУ СИМУЛЯТОР ТИМФАЙТА 5 на 5 / ATOMIC WAR / Дота 2
Патогенные кокки

Свирск День города Улица снов

Погода на Соловьев Лайф: рекордно тёплый старт ноября отсрочит зиму на 1-2 недели. #часовойпогоды

Ирина Кузьменко. Особенности летних занятий в детском клубе

Стоит ли заводить собаку?

Спустило колесо. Причина неизвестна.

Как надо принимать ванну

4-7-8 Guided Breathing

Адай куйы жарды поезды ?
За каждым успешным каналом стоит личность, идея и сотни часов кропотливого труда. Если вы здесь, значит, автор «Путешествия по невидимому миру» уже сумел зацепить ваше внимание своим уникальным стилем или подачей. А мы на RUVIDEO позаботились о том, чтобы вы могли изучить весь архив его работ в максимально комфортных условиях — без лишней суеты и преград.
Почему за работами канала «Путешествия по невидимому миру» так интересно наблюдать? Всё просто: это честный контент, который находит отклик в сердцах зрителей. На нашем ресурсе вы можете смотреть онлайн все видео любимого автора бесплатно и в хорошем качестве. Нам важно, чтобы вы видели каждую деталь и слышали каждый нюанс, поэтому мы используем только стабильные плееры из открытых источников Rutube.
Следите за новинками канала, пересматривайте старые шедевры и открывайте для себя новые грани творчества «Путешествия по невидимому миру». Мы постоянно обновляем ленту, чтобы у вас под рукой всегда были самые свежие выпуски. Никаких сложных регистраций — только вы и творчество, которое вдохновляет. Приятного вам путешествия по миру авторского контента на RUVIDEO!
Видео взято из открытых источников Rutube. Если вы правообладатель, обратитесь к первоисточнику.